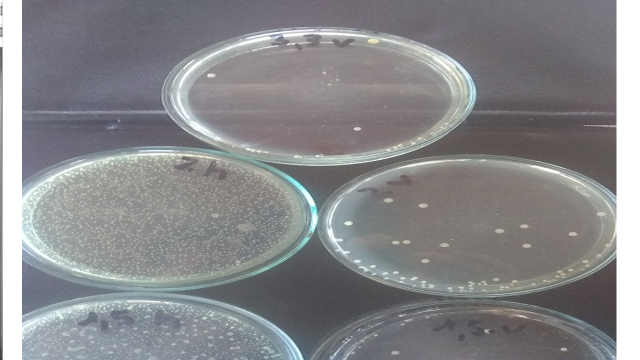

Introducción
Cuando el ser humano padece enfermedades respiratorias bacterianas o virales tales como resfríos anginas y gripes, ocurren reacciones fisiológicas, tos y estornudos para que las mucosas puedan expulsar parte de los gérmenes, células muertas y endotoxinas acompañadas de moco.
Estos reflejos naturales, generan gotitas biológicas denominadas Flüge, lanzadas a gran velocidad hacia el aire que rodea a la persona infectada, poniendo en riesgo a las personas cercanas.
AFIRMACIÓN ERRÓNEA DE LA COMUNIDAD MÉDICA
Gran parte de la comunidad médica de nuestro país y algunos facultativos del exterior, afirman que el corona virus 2019 SARS 2, es una partícula pesada que precipita al piso antes del metro y medio de distancia en sentido horizontal a partir de la persona que habla tose o estornuda. Esto no concuerda con la opinión del Dr. Kasuhiro Tateda director de la Sociedad de Infectología de Tokio en Japón, que sostiene que la propagación va mucho más allá de los 6 metros.
Lo que afirman nuestros médicos significa desconocer las leyes de Galileo y Newton sobre de caída de los cuerpos y la física del comportamiento de gotitas pequeñas y aerosoles en la atmósfera.
CONSIDERACIONES FÍSICAS
Todos los cuerpos caen en el vacío con la misma aceleración y velocidad, en tanto que la caída en el aire se ve influenciada por las fuerzas de roce, tal es el caso del paracaídas.

1-Hombres en caída libre bajo la aceleración de la gravedad g = 9,8 m/s2

2-Hombre cayendo a velocidad constante por el rozamiento del paracaídas con el aire.
En la caída de gotitas, entran a jugar algunos factores tales como el diámetro, la viscosidad del aire, la aceleración de la gravedad que es prácticamente constante.

3-Piedras cayendo todas a igual velocidad independiente
de su tamaño y peso.

4-Gotas grandes cayendo a igual velocidad independiente de sus tamaños.
El rigor científico nos llevó en la Universidad Tecnológica Nacional, Facultad Regional Tucumán a revisar estos conceptos y realizar mediciones en condiciones experimentales y controladas de laboratorio.
PRIMER EXPERIMENTO
Usando un picnómetro se comparó la densidad de un caldo de cultivo estéril (sin gérmenes) con otro conteniendo 1.500 millones de estreptococos termófilos por ml, los cuales son 5 veces más grandes y pesados que el corona virus 19 SARS2.

5-Caldo estéril densidad 1,0023, 1 gota estándar pesa 0,05011 gr

6-Caldo turbio infectado, densidad 1,0030, 1 gota estándar pesa 0,05015
Con estos resultados podemos afirmar que una gota de caldo estéril pesa prácticamente lo mismo que una gota de caldo poblado con millones de gérmenes, independiente que sean virus o bacterias.
Con los resultados anteriores se puede afirmar que el peso de una gotita biológica infectada o no, es muy parecido al de una gota de agua y no depende del microorganismo que contenga, aún en cantidades astronómicas. Se usó la escala de McFarland para medir cantidades muy altas de gérmenes.
SEGUNDO EXPERIMENTO
Se estudió el comportamiento de un aerosol biológico en un ambiente cerrado y cómo se propagan las gotas de las mucosidades respiratorias humanas. En el pasillo desinfectado de una vivienda, se disponen cajas de cultivo estériles en posición horizontal y vertical colgadas de alambres tensores, tal como se observa en la próxima imagen.

7- Pasillo de 4 m donde se realizó la simulación
Luego se simula y expulsa en dirección a las cajas un estornudo con caldo de cultivo infectado con estreptococos 5 veces más grandes que el covid 19 SARS 2 con igual viscosidad que las secreciones humanas; se esperan 10 minutos que dichas bacterias impacten las cajas de cultivos, luego se tapan las mismas y se las cultiva en el laboratorio a 37 °C para comprobar hasta qué distancia llegaron los microbios ensayados.

8-Vista al microscopio de los estreptococos de 1 micrón de diámetro utilizados, es decir 5 veces mas grandes que el virus covid19 SARS2.
RESULTADOS DE LA EXPERIENCIA
Transcurridas 72 horas de cultivo de las cajas, se obtuvieron los siguientes resultados:
9-Las cajas con letra h fueron colocadas en posición horizontal a 35 cm del piso, y las cajas con letra v en posición vertical a la altura de nariz de una persona tomando 1,65 metros desde el piso.
Nota / Cada puntito de color blanco cremoso, representa una unidad formadora de colonia (ufc) conteniendo miles de estreptococos, que se formaron por división (mitosis) a partir de una célula madre que impactó sobre la placa de cultivo durante la experiencia de proyectar el spray o estornudo simulado.

10-Imagen de la web. En verde se ven las gotículas mas voluminosas que caen cerca de la persona emisora, en rojo los núcleos infecciosos compuestos por gotículas muy finas menores de 10 micrones que se propagan indefinidamente y no sedimentan nunca, aunque pueden perder poder infectivo por desecación y en lugares abiertos por la radiación natural de la luz solar.
TERCER EXPERIMENTO


12-Una persona hace buches con fenolftaleína y habla sobre un papel secante, el revelado con hidróxido de sodio, muestra los impactos de las gotitas.
INTERPRETACIÓN Y CONCLUSIONES
.Puede verse claramente en la imagen (10) de la web, que la mayor parte de las gotitas que transportan gérmenes llegan en gran cantidad hasta los 1,82 metros de distancia , si embargo en nuestros experimentos encontramos gérmenes hasta 3,30 metros y seguramente alcanzan distancias mayores, imagen (9).
.Se nota que las cajas de cultivo expuestas horizontalmente están mas pobladas de gérmenes que las placas verticales (9) a la derecha, que reciben mucha menor cantidad, esto se debe a la trayectoria de caída en forma de parábola que establece la física en un tiro horizontal.
.Observando en la placa vertical situada a 3,3 metros de la fuente simuladora de estornudos imagen (9) contiene 28 colonias, la mayoría de las cuales impactaron en la parte inferior del disco debido a la trayectoria de caída por el efecto de la gravedad, tal como se puede observar con las gotitas verdes de la imagen (10).
.La separación social de 1,5 y 2 metros que propone la comunidad médica es insuficiente, ya que se registran gotículas y gérmenes mas allá de estos límites.
.La imagen (11) muestra lo que debemos evitar y la (12) revela la cantidad de gotitas que emitimos al hablar, se determinaron 200 gotitas por minuto; las gotitas mas gruesas pueden contener hasta 10.000 virus , en tanto que si ingresamos 1.000 partículas virales por naríz boca u ojos (dosis infectiva), es suficiente para infectarnos con el covid19 SARS 2 y el curso de la enfermedad dependerá de cuan fuerte esté nuestro sistema inmune.
Lic. Juan Carlos Luján
Investigador Área Química, Universidad Tecnológica Nacional-Tucumán

Ventana del Norte



